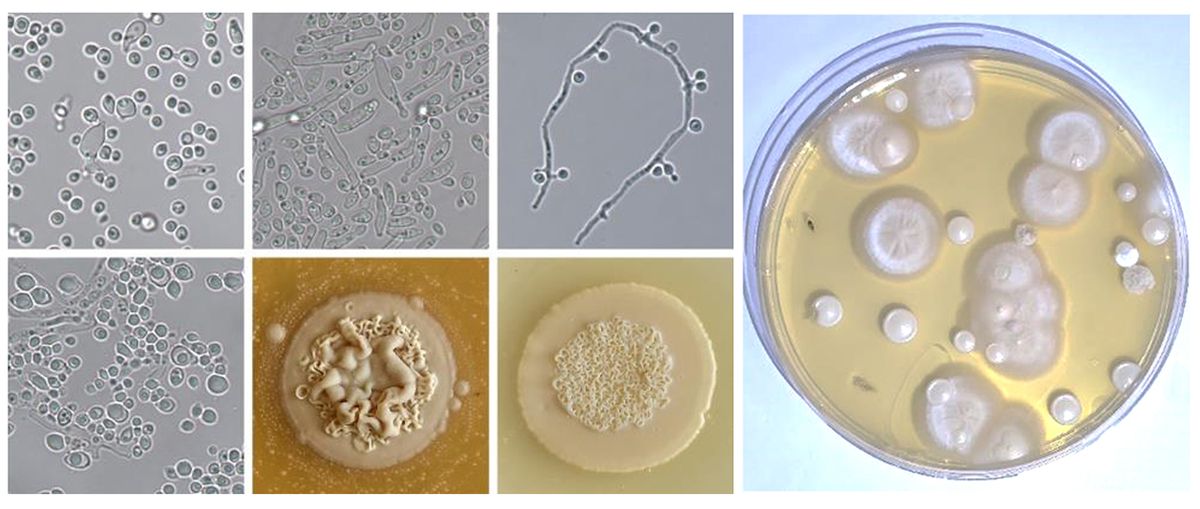

Článek
Vzácný brouk žijící v evropských lesích dovedl vědce k překvapivému objevu. Tento mimořádný nález ukazuje, jak málo je svět mikroorganismů v evropských lesích prozkoumaný. Studie odborníků z České a Slovenské akademie věd vyšla v mezinárodním mykologickém časopise IMA Fungus.
Brouk, který si pěstuje potravu
Jádrohlod jedlový (Treptoplatypus oxyurus) patří mezi takzvané ambrosiové brouky, kteří jsou výjimeční tím, že si ve dřevě doslova „zakládají zahrádky“. Neživí se totiž samotným dřevem, ale houbami, které v něm pěstují.
Tato spolupráce mezi brouky a houbami není žádná novinka – podle vědců vznikla už před desítkami milionů let a patří k nejstarším známým „zemědělským“ systémům v přírodě.
Mohutné staroduby na Soutoku měly namále, konečně jich přibývá. Objevil se i sto let nezvěstný brouk

Do této skupiny hmyzu patří tisíce druhů po celém světě, v Evropě jsou ale původní jen dva. Některé příbuzné druhy jsou známé i jako významní lesní škůdci, protože napadají oslabené stromy a pomáhají šířit houby, které je dále poškozují. „Ve speciálních orgánech přenášejí houby, které pak v chodbičkách aktivně pěstují a živí se jimi,“ vysvětluje entomolog Jiří Hulcr.
Právě díky těmto houbám dokáže brouk získávat živiny ze dřeva, které by pro něj jinak zůstaly nedostupné.
Ostrov biologické rozmanitosti
Vědce překvapilo, kolik neznámých organismů ve vzorcích našli. Mezi pěti hlavními houbami byl jeden zcela nový rod a tři nové druhy; další identifikované druhy patřily mezi extrémně vzácné.
Podle autorů studie jde o neobvykle vysokou koncentraci dosud nepopsaných nebo velmi vzácných organismů na jediném místě – v těle brouka a v jeho chodbičkách ve dřevě. „Taková koncentrace nových organismů je mimořádná. Lze ji přirovnat ke Galapágám,“ uvádí hlavní autor studie Miroslav Kolařík.
Přirovnání odkazuje na jihoamerické souostroví známé vysokým podílem původních, jedinečných druhů. Podobně i v tomto případě vědci narazili na „ostrov“ biologické rozmanitosti, který byl dosud skrytý a prakticky neprozkoumaný.
Houby stromům škodí i pomáhají
Objevené houby ale nehrají roli jen v životě samotného brouka. Některé druhy oslabují obranyschopnost stromů, nebo je dokonce dokážou zahubit, což broukům usnadňuje jejich kolonizaci. Jiné naopak rozklad dřeva ovlivňují – mohou ho urychlovat, ale i zpomalovat, a tím měnit podmínky pro další organismy.
Podobné vztahy mezi brouky a houbami jsou známé i z jiných částí světa, kde některé příbuzné druhy způsobují rozsáhlé škody v lesích, zejména pokud jsou stromy oslabené suchem nebo jiným stresem.
Vedle toho ale mohou mít nově objevené houby i praktické využití. Vědci u nich zkoumají například schopnost rozkládat různé cukry obsažené ve dřevě, což by mohlo najít uplatnění v biotechnologiích nebo potravinářství.
Houby izolované z těla brouka. Vědci na jediné misce našli hned několik druhů hub, včetně tří dosud neznámých.
Výzkum ukazuje, že i evropské lesy mohou skrývat dosud neprozkoumané mikrobiální ekosystémy. „Je to důkaz, že i v dobře prozkoumaném prostředí můžeme nacházet zcela nové organismy,“ uvádějí vědci. Podle nich tak podobné objevy naznačují, jak málo zatím víme o mikroorganismech spojených s běžnými druhy rostlin a živočichů.



